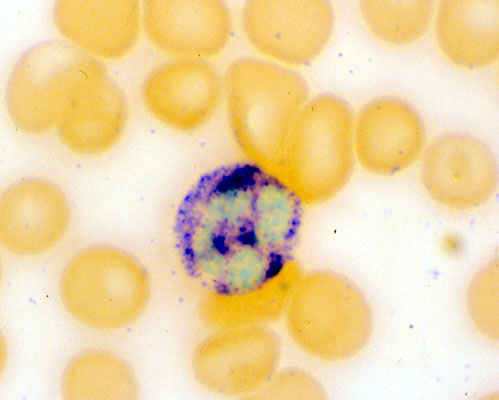

Neutrophil, positive staining with chloracetate esterase, peripheral blood
Click picture to enlarge. Close window to return
Granulocytes have cytoplasmic granules which contain a variety of enzymes which can be detected by cytochemical staining. This normal neutrophil shows numerous cytoplasmic granules which stain positive for CAE.